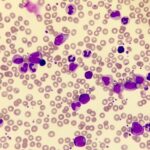
سرطان خون ملوئیدی مزمن

سرطان خون ملوئیدی مزمن و هر آنچه که باید راجب این سرطان بدانید!
سرطان زمانی شروع میشود که سلولهای بدن شروع به رشد بیش از حد میکنند. سلولها تقریباً در هر قسمت از بدن میتوانند به سرطان تبدیل شوند و به سایر قسمتهای بدن گسترش یابند. سرطان خون میلوئیدی مزمن (CML) نوعی سرطان است که گلبولهای سفید خون را تحت تأثیر قرار میدهد. این بیماری در هر سنی […]